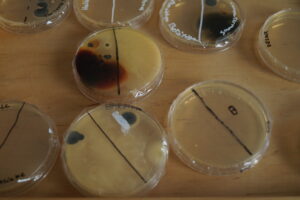

DIGITALE KONFERENZ ZUR
Differenzierung beim forschenden Lernen (Schwerpunkt Experimentieren)
Angebote in deutscher Sprache
Dem Einsatz von heterogenen Lerngruppen im Unterricht wird immer wieder ein großes Potenzial zur Verbesserung der Lernerfahrung zugeschrieben. Während es für das Erlernen inhaltsbezogener Kompetenzen bereits viele Differenzierungskonzepte und Praxisbeispiele gibt, fehlen diese für prozedurale Kompetenzen – insbesondere im Bereich des naturwissenschaftlichen Experimentierens.
Ziele dieser Konferenz sind:
- Die Präsentation und Diskussion neuer Forschungsergebnisse zum forschenden Lernen (04.07.2022).
- Die Entwicklung innovativer Forschungsideen zum forschenden Lernen (04.07.2022).
- Die Vernetzung von Lehrpersonen und Forscher:innen (04./05.07.2022).
- Die Weiterentwicklung des Unterrichts zum forschenden Lernen (05./06.07.2022).
Die Angebote am 04.07.2022 werden in englischer Sprache abgehalten. Am 05.07.2022 ist die Abhaltungssprache Englisch mit deutschsprachiger Unterstützung. Die Angebote am 06.07.2022 werden in deutscher Sprache abgehalten.

Programm

Anmeldung
Die Teilnahme an der gesamten Konferenz ist kostenlos. Die Lehrerfortbildung am 06.07.2022 ist Teil des offiziellen Fortbildungsprogramm der PH Salzburg und kann als offizielle Fortbildung angerechnet werden.
Zur Anmeldung klicken Sie bitte hier.
Für weitere Informationen und Fragen nutzen Sie bitte unsere E-Mail Adresse:





